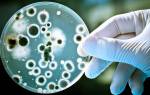

Эритроциты (BLD)
Лейкоциты (LEU)
ПОКАЗАТЕЛЬ
НА БЛАНКЕ ЭЛЕКТРОННОГО АНАЛИЗА
НОРМАЦвет
Color
Желтый (все оттенки, от соломенно желтого до желтого)ЗапахНе резкийВнешний вид
Clarity
ПрозрачнаяОтносительная плотность или удельный вес
SG
Взрослые – 1010-1025 (в утренней моче – 1018-1026)
- Новорожденные – 1005-1017;
- 1-4 года – 1007-1016;
- 5-10 лет – 1011-1021;
- 11-15 лет – 1013-1024;
Кислотно-щелочная реакция рН
- у детей 4,5-8
- у взрослых 5,11-7,08
Белок
PRO
- у детей отсутствует
- у взрослых 0-0,1389 г/л
Глюкоза
GLU
- у детей отсутствует
- у взрослых 0-1,0 ммоль/л (0,33-0,154 г/л)
Кетоновые тела или ацетон KET
- у детей — отсутствуют
- у взрослых 0-0,52 ммоль/л (0,02-0,05 г/сутки)
Лейкоциты
LEU
- у мальчиков: Negative или 0-1-2 в поле зрения
-
у девочек: Negative или 0-2 и до 8-10 в ПЗ
- У мужчин: до 5 в п/зр
- У женщин: до 10-15 в п/зр
Уробилиноген
UBG
До 17 мкмоль/л (umo/L)
Эритроциты
BLD
- у детей 0-1/ Negative
-
у взрослых 0-1-2-3 в поле зрения
Эпителиальные клетки (плоский эпителий) эп. или эп. кл.Цилиндры (гиалиновые цилиндры) цилБилирубинBILОтсутствуют / NegativeБактерии
NIT
Кристаллы солейназвания солей пишут от рукиГрибы—Слизь—
Расшифровка показателей общего анализа мочи является оценкой всех химических и физических параметров в комплексе. Увеличение или снижение ниже нормы одного из химических соединений не является критичным и должно подтверждаться с помощью дополнительных исследований состояния организма.
Моча представляет собой биологическую жидкость, содержащую около 150 различных элементов. Ее состав изменяется в зависимости от психического или физического состояния человека, потребленной жидкости и пищи.
Клинический анализ мочи является обязательной диагностической процедурой, которую назначают практически всем пациентам любого медицинского учреждения. Данный метод лабораторной диагностики позволяет получить сведения о различных обменных процессах, происходящих в человеческом организме, функциональном состоянии мочевыводящей системы.
Во время исследования пробы биологического материала проводят измерение относительной плотности (удельного веса), уровня кислотности среды и содержания белка, глюкозы, желчных пигментов, кетоновых тел и некоторых других показателей.
В современных лабораторных центрах тестирование мочи выполняется на специальных приборах – анализаторах. Результаты исследования выдаются в виде таблицы с латинскими буквами, непонятными пациентам, к примеру – анализ мочи sg.
В нашей статье мы расскажем о правилах сбора биологического материала, какие диагностические показатели мочи измеряются при общеклиническом исследовании и о наличии каких заболеваний могут означать их отклонения от нормы.
Аббревиатура UBG в анализе мочи является показателем концентрации уробилиногена. Присутствие уробилиногена в урине — норма. Повышение UBG происходит по ряду причин и заболеваний.
UBG (уробилиноген) в анализе мочи выявляется в результате изучения биоматериала посредством общего исследования урины в лабораторных условиях. Общий анализ мочи считается объединяющим информативным исследованием фактически всех систем деятельности организма человека. Стоит разобраться, какова норма концентрации уробилиногена в моче, и что выявляет повышение показателя.
Анализ мочи соответствует норме, если:
- BIL, KET, BLD, PRO, NIT, LEU, GLU – отсутствуют (на бланке отмечаются символом «Neg»);
- UBG менее 17 umol/L;
- SG – в пределах 1,008 – 1,030;
- pH – 5 -7.
Следует знать, что общеклинический анализ мочи определяет лишь общую картину возможной патологии. Для точной постановки диагноза необходимы дополнительные методы исследования.
ПоказательНормаПричины повышенного содержанияПричины пониженного содержания или отсутствияОбщая плотность SG1,008 – 1,030 г/лБолее 1,030 г/л – при недостаточном потреблении жидкости, нарушении функции почек, отеках, гломерулонефрите в острой стадии, сахарном диабете.1,010 – 1,011 – при нарушении функции почек; Менее 1,005 – несахарный диабет; Менее 1,015 – при диетах, потреблении жидкости в большом количестве, уменьшении отеков.Уробилиноген UBGНе более 17 умол/л; В бланках старого образца содержание уробилина фиксируют, — слабо положительный, — положительный, — резко положительный, что указывает на степень уробилинурииФункциональные нарушения печени: гепатиты, интоксикация (отравления алкоголем, хим. соединениями, при сепсисе); циррозы, печеночная недостаточность.___Билирубин BILНе определяетсяПеченочная и механическая желтуха___Кетоновые тела KETНе определяютсяДиабеты 1 и 2 типа, сильное повышение кетонов наблюдается при коме; Долговременные диеты, отравление алкоголем, послеоперационный период___Эритроциты BLDНе выявляютсяПиелонефриты и гломерулонефриты в процессе обострения, простатит, травмы и очаги воспаления в почках и мочевыводящих путях, туберкулез, инфаркт, рак почек.Не более 3 в поле зрения, что может случаться при физическом перенапряженииБелок PROМенее 0,002 г/лИнфекции и очаги воспаления в почках и мочевыводящих путях, туберкулез почек, амилоидоз, кровотечения, гипертония, длительно протекающая анемия.___Нитриты NITНе определяютсяИнфицирование мочевых путей патогенными бактериями___Лейкоциты LEUДо 3 у мужчин и до 5 у женщинБолезни почек в острой и латентной фазе: пиелонефрит, гломерулонефрит; воспаления мочевыводящих путей, амилоидоз и туберкулез почек___Глюкоза GLUНе выявляетсяПочечный диабет___Реакция рН5 — 7Сахарный диабет, длительные голодания, туберкулез почек, функциональные нарушения почекЦиститы, гематурия, после рвоты и промывания желудка,
Правильная расшифровка общего анализа мочи возможна только при условии наличия исчерпывающей информации о составляющих компонентах урины. Рассмотрим более подробно, что означает каждый из биохимических показателей собранной мочи, и на что указывает отклонение от нормы.
Оценка концентрации уробилиногена является обязательной частью при проведении общего (клинического) исследования мочи. Этот показатель обозначается как ubg или uro в анализе мочи.
Направление на анализ может выписать любой доктор, у которого имеются подозрения на нарушение состояния работы печени или мочевыделительной системы, а также при симптоматических проявлениях и жалобах пациента.
Нормы и расшифровка результатов общего анализа мочи у взрослых (таблица)
1. Цвет мочи
Норма: соломенно-желтый.
Изменение цвета мочи может быть обусловлено продуктами питания, лекарствами или являться признаком некоторых заболеваний.
Цвет мочи
Возможная причина изменения цвета
Бледно-жёлтый, светлый
Несахарный диабет, приём мочегонных препаратов, снижение концентрационной функции почек, избыточное содержание воды в организме
Тёмно-жёлтый
Обезвоживание, отёки, рвота и понос, ожоги. Отёки при сердечной недостаточности
Цвет пива
Желтуха паренхиматозная при вирусном гепатите
Оранжевый, жёлто-оранжевый
Фурагин, Фуромаг, витамины группы В
Красный
Инфаркт почки, почечная колика
Цвет «мясных помоев», красно-бурый
Острый гломерулонефрит
Розовый
Свекла, черника, аспирин
Красно-коричневый
Отравление фенолом. Приём сульфаниламидов, метронидазола, лекарств на основе толокнянки
Зеленовато-желтый цвет
Механическая желтуха (вследствие закупорки желчных протоков) при раке головки поджелудочной железы или при наличии камней в желчном пузыре (калькулёзный холецистит)
Бело-молочный
Капли жира, гной или неорганический фосфор
Черный цвет
Меланома, алкаптонурия (наследственное заболевание), болезнь Маркиафава-Микелли (пароксизмальная ночная гемоглобинурия)
2. Прозрачность мочи
Норма: прозрачная.
Мутная моча может быть обусловлена слизью и эпителием. При хранении мочи при низкой температуре её соли могут выпадать в осадок и обусловливать мутность. Длительное хранение материала для исследования приводит к размножению в нём бактерий и помутнению мочи.
3. Удельный вес или относительная плотность
Норма для детей старше 12 лет и взрослых: 1010 – 1022 г/л.
На удельный вес мочи влияет количество выделяемой жидкости, органических соединений (солей, мочевины), электролитов – хлора, натрия и калия. Чем больше воды выделяется из организма, тем более «разбавленной» будет моча и тем ниже её относительная плотность или удельный вес.
Снижение (гипостенурия): менее 1010 г/л.
- Наблюдается при почечной недостаточности, когда нарушается концентрационная способность почек.
- Несахарный диабет;
- Хроническая почечная недостаточность;
- Употребление большого количества воды, приём мочегонных препаратов.
Повышение (гиперстенурия): более 1030 г/л.
Присутствие белка или глюкозы в моче. Встречается при:
- сахарном диабете, плохо отвечающем на проводимую терапию;
- появлении белка в моче при гломерулонефрите;
- внутривенном введении рентгеноконтрастных веществ, растворов декстрана или маннитола;
- недостаточном употреблении жидкости;
- токсикозе беременных.
4. Реакция мочи (рН мочи)
Норма: 5,5-7,0, кислая или слабокислая.
На реакцию мочи влияет характер питания и наличие заболеваний в организме. Если человек предпочитает мясную пищу, то реакция мочи кислая. При употреблении фруктов-овощей и молочных продуктов происходит сдвиг реакции в щелочную сторону. Кроме особенностей питания, возможны следующие причины.
Щелочная реакция, рН > 7, повышение рН:
- хроническая почечная недостаточность,
- алкалоз дыхательный или метаболический,
- почечный канальцевый ацидоз (тип I и II),
- гиперфункция паращитовидной железы,
- гиперкалиемия,
- длительная рвота,
- опухоли мочевыделительной системы,
- инфекции мочевыводящих путей и почек, вызванные расщепляющими мочевину бактериями,
- приём адреналина или никотинамида (витамина РР).
Кислая, рН около 4, снижение рН:
- ацидоз дыхательный или метаболический,
- гипокалиемия,
- голодание,
- обезвоживание организма,
- длительная лихорадка,
- сахарный диабет,
- туберкулёз,
- приём витамина С (аскорбиновой кислоты), метионина, кортикотропина.
1. Белок в моче
Норма: отсутствует.
Появление белка в моче – сигнал о неблагополучии в работе почек. Исключением является физиологическая протеинурия (белок в моче), которая наблюдается при выраженной физической нагрузке, сильном эмоциональном переживании или переохлаждении. Допустимое содержание белка – до 0,033 г/л, оно не определяется обычными реактивами для выполнения общего анализа мочи.
Повышение: более 0,033 г/л.
Возможные причины:
- поражение почек при сахарном диабете (диабетическая нефропатия),
- нефротический синдром,
- гломерулонефрит,
- миеломная болезнь,
- инфекции мочевых путей: уретрит, цистит,
- злокачественные новообразования органов мочеполовой системы.
2. Глюкоза в моче
Норма: отсутствует.
Во время фильтрации в почечных канальцах глюкоза у здоровых людей полностью всасывается обратно. Поэтому она не обнаруживается или бывает в минимальных количествах – до 0,8 ммоль/л.
1. Содержание её в крови превысило 10 ммоль/л вместо допустимых 5,5 ммоль/л, поэтому почки просто не смогли произвести её обратное всасывание. Это возможно при сахарном диабете, остром панкреатите, гипертиреоидизме, инфаркте миокарда, ожогах, обширных повреждениях, при феохромоцитоме (опухоль надпочечников).
2. Поражены почечные канальцы, поэтому не происходит обратное всасывание глюкозы. Встречается при отравлении стрихнином, морфином, фосфором; тубулоинтерстициальных поражениях почек.
3. Билирубин в моче
Норма: отсутствует.
Билирибун появляется в моче, когда его концентрация в печени значительно превышает нормальные значения. Это встречается при повреждении паренхимы печени (вирусный гепатит, цирроз печени) либо при механической закупорке желчного протока и нарушении оттока желчи (механическая желтуха, метастазы опухолей других органов в печень).
4. Уробилиноген в моче
Норма: отсутствует.
Уробилиноген образуется из билирубина, который является результатом разрушения гемоглобина.
Повышение: более 10 мкмоль/сутки.
А) Повышенный распад гемоглобина (гемолитическая анемия, переливание несовместимой крови, рассасывание крупных гематом, пернициозная анемия).
Б) Усиленное образование уробилиногена в кишечнике (обструкция кишечника, энтероколит, илеит.
В) Повышение уровня уробилиногена в крови при заболеваниях печени (хронический гепатит и цирроз печени) или токсическом поражении (алкоголь, токсины бактерий).
5. Кетоновые тела
Норма: отсутствуют.
К кетоновым телам относится ацетон и две кислоты – ацетоуксусная и бета-оксимасляная. Они образуются при усиленном разрушении жирных кислот в организме. Их определение важно для наблюдения за пациентами с сахарным диабетом. Если в моче обнаруживаются кетоновые тела, значит, инсулинотерапия подобрана неправильно.
Состояния, сопровождающиеся появлением кетоновых тел в моче:
- сахарный диабет декомпенсированный,
- гипергликемическая мозговая кома,
- тяжёлая лихорадка,
- длительное голодание,
- эклампсия у беременных,
- отравление изопропронололом,
- алкогольная интоксикация.
6. Нитриты в моче
Норма: отсутствуют.
У здорового человека нитритов в моче нет. Они образуются под влиянием бактерий из нитратов в мочевом пузыре, если моча находится в нём более 4 часов. Если в моче появились нитриты – это признак инфекции мочевого тракта. Чаще других бессимптомные инфекции мочевыводящих путей отмечаются у женщин, у пожилых людей старше 70 лет, у больных сахарным диабетом или подагрой, при аденоме простаты.
7. Гемоглобин в моче
Норма: отсутствует.
При выполнении анализа практически невозможно различить миоглобин и гемоглобин. Поэтому часто появление в моче миоглобина лаборант описывает как «гемоглобин в моче». Оба белка не должны появляться в моче. Наличие гемоглобина свидетельствует о:
- тяжёлой гемолитической анемии,
- сепсисе,
- ожогах,
- отравлении ядовитыми грибами, фенолом, сульфаниламидами.
Миоглобин появляется при:
- изнурительных физических нагрузках (бывает у спортсменов),
- рабдомиолизе,
- инфаркте миокарда.
Цвет мочи
Запах мочи
Белок в моче (PRO)
Билирубин (BIL)
Уробилиноген (URO)
Эритроциты (BLD)
Лейкоциты (LEU)
Расшифровка общего анализа мочи у ребенка соответствует принципам взрослой диагностики. Особенности – более гибкие показатели у детей до 5 лет. В моче ребенка, в отличие от взрослого человека, допустимы:
- Белок;
- Глюкоза;
- Уробилиноген;
- Кетоны;
- Билирубин;
- Соли.
Такие составляющие объясняются ранним возрастом детей и особенностями рациона питания. Клеточные вкрапления (лейкоциты, эритроциты) должны строго соответствовать «взрослым» нормам. Карточку с результатами общего анализа мочи необходимо показать педиатру в обязательном порядке.
Лабораторное исследование мочи на предмет концентрации общих показателей, проводится по тому же самому принципу, как и в случае диагностики взрослой мочевыделительной системы. Существуют только некоторые особенности в расшифровке общего анализа урины у детей возрастом до 5 лет. В составе детской мочи допускается присутствие следующих компонентов, наличие которых должно полностью отсутствовать у взрослых людей:
- белковые соединения;
- минеральные соли;
- кетоновые тела;
- глюкоза;
- билирубин;
- уробилиноген.
Наличие таких клеток, как лейкоциты или эритроциты, не допускается независимо от возрастной группы ребенка. Данные показатели общего анализа мочи должны строго соответствовать взрослым нормам. Их появление — это первый тревожный сигнал возможной проблемы со здоровьем, оценку которой даст только врач педиатр.
Расшифровка показателей общего анализа у женщин, находящихся в состоянии беременности, выполняется по тому же самому принципу, как и у обычного взрослого человека. Единственное на что делается акцент, так это на регулярный забор биологического материала для исследования на предмет скрытой бактериурии. В период беременности у женщин часто возникает инфекционное воспаление мочевого пузыря, которое требует своевременного лечения.
Физические свойства: цвет, плотность и прозрачность должны соответствовать следующим параметрам:
- Цвет – от светло-желтого до желтого;
- Плотность – 1,008 – 1,030 г/л;
- Прозрачность – прозрачная или слабо-мутная.
При исследовании химических свойств, нормальными показателями считаются:
- рН (среда) – кислая (от 5 до 7);
- Белок содержится в незначительных количествах и химическим путем не определяется;
- Уробилин – менее 17 умоль/л.
Все остальные показатели должны быть равны нулю.
У взрослых людей моча исследуется по нескольким параметрам. Норму и патологию рассмотрим ниже.
Прозрачность
Моча должна быть прозрачной, если она мутная, то возможно:
- Наличие белка в моче — амилоидоз, пиелонефрит, гломерулонефрит
- Наличие эритроцитов — рак почки, мочевого пузыря, мочекаменная болезнь, простатит, пиелонефрит, гломерулонефрит
- Бактерии в моче — цистит, пиелонефрит
- Наличие лейкоцитов — пиелонефрит, цистит
- Эпителий в моче — пиелонефрит
- Выпадение в осадок солей (фосфаты, ураты, оксалаты)
Эпителий
Эпителиальные клетки всегда встречаются в анализе. Попадают они туда, слущиваясь со слизистой оболочки мочевыводящих путей. В зависимости от происхождения выделяют переходный vtc (мочевой пузырь), плоский (нижние отделы мочевыводящих путей) и почечный (почки) эпителий. Увеличение эпителиальных клеток в мочевом осадке говорит о воспалительных заболеваниях и отравлениях солями тяжелых металлов.
Сдаёте анализы в частной клинике?
ДаНет
В моче у здоровых людей определяются следы плоского эпителия
. Повышенное содержание обнаруживаются при наличии очагов воспаления в мочевом пузыре и почечных лоханках, образовании камней в органах мочевыделительной системы.
У мужчин увеличение численности эпителиальных клеток наблюдается при воспалениях уретры и предстательной железы.
Цвет
Цвет выделяемой нами жидкости обеспечивает пигмент урохром (продукт обмена билирубина). Изменение окраски материала может свидетельствовать о различных патологиях, также наблюдается при употреблении определенной пищи и лекарств:
- красноватый, красный, цвет «мясных помоев» — говорит о наличие эритроцитов (гематурия), то есть крови в моче (мочекаменная болезнь, цистит, гломерулонефрит), а также при наследственной порфиринурии, свинцовой интоксикации, при тяжелых токсикозах, приеме противотуберкулезных препаратов (рифампицин), фенацетина, препаратов железа, сульфазола, красного стрептоцида, амидопирина.
- темно-желтый с коричневатым или зеленоватым оттенком – выделение большого количества билирубина и желчных пигментов при механической желтухе (желчь застаивается и не поступает из желчного пузыря в кишечник), заболеваниях печени, гемолитическая анемия.
- темно-желтый — концентрированная моча, обычно бывает при малом употреблении жидкости, усиленном потоотделении, а также при употреблении моркови. При обезвоживании (рвота, диарея, высокая температура), а также при голодании, у детей при нехватке грудного молока, при болезнях сердца и печени.
- зеленовато-желтый – обилие гноя (пиурия);
- грязно-коричневый – пиурия при щелочной реакции;
- черный и буро-черный– выделение гемоглобина при гемолитической анемии (гемоглобинурия), меланина при меланоме, меланосаркоме, болезнь Маркиафава-Микели, отравлении нафтолом
- белый, беловатый – большое количество фосфатов (фосфатурия), жиров (липурия) или лимфы (опухоли мочевыделительной системы или туберкулез почек).
- прозрачный, бледная моча – безобидные причины: прием мочегонных средств и продуктов (см. мочегонные народные средства), обильное питье. Патологические причины — несахарный диабет, нарушение концентрирующей функции почек;
- розовый – наличие фенолфталеина при щелочной реакции;
- темно-бурый – употребление сульфаниламидов (бисептол), метронидазола, препаратов на основе толокнянки;
- зеленовато-бурый – прием индометацина, амитриптилина;
- оранжево-желтый – после введения витаминов группы В, С, поливитаминных комплексов, а также приема пищи с бета-каратином — хурма, абрикосы, морковь, ярко оранжевые фрукты и овощи.
Лейкоциты в моче
Обнаружение большого количества этих клеток в моче всегда говорит о воспалительном процессе в мочевыделительной системе, будь то цистит или пиелонефрит. Если количество белых клеток крови более 60 в поле зрения, это называется пиурия (гной в моче). В анализе могут встречаться как нейтрофилы, так и лимфоциты. При хроническом воспалении лейкоциты – более верный показатель, чем бактерии, которые не всегда обнаруживаются.
В моче здорового человека эритроциты отсутствуют или определяются в виде единичных клеток (0-1-2-3 в поле зрения). В норме их появление связано с тяжелым физическим трудом, занятием спортом. У женщин эритроциты могут попадать в анализ при менструации или беременности.
В зависимости от количества эритроцитов в моче выделяют:
- легкую эритроцитурию – до 20 клеток в микроскопе;
- средней тяжести – от 20 до 200 клеток;
- выраженную эритроцитурию (гематурия) – более 200 клеток в поле зрения.
В зависимости из какого отдела мочевыделительной системы эритроциты попадают в мочу, они обнаруживаются выщелоченные или в неизмененном виде. Причины наличия эритроцитов в моче:
- травмы почек — надрыв, ушиб, разрыв
- мочекаменная болезнь
- инфаркт почки
- уретрит, цистит, острый гломерулонефрит
- рак мочевого пузыря, рак почки, рак простаты
- гломеруло- и пиелонефриты (острые и хронические);
- мочекаменная болезнь;
- острый цистит;
- инфаркт почки;
- рак почки и мочевого пузыря;
- аденома предстательной железы;
- травма мочеполовой системы;
- геморрагический диатез;
- системная красная волчанка;
- геморрагическая лихорадка (Эбола, Крымская, Конго);
- амилоидоз почки;
- отравление бензолом, анилином, змеиным ядом;
- туберкулез почек;
- липоидный нефроз.
Более подробно в статье Причины появления крови в моче
Уробилиноген — это вещество, образующееся из выделившегося с желчью билирубина в просвете кишечника. Из кишечника частично он возвращается в кровь и с током крови поступает в печень, где выводится с желчью повторно. Если печень связать весь поступивший уробилиноген не в состоянии, часть его поступает в общий кровоток, тогда этот уробилиноген из организма выводится почками. Причинами выделения уробилиногена в моче:
- печеночная недостаточность
- воспаление кишечника — колит, энтероколит
- массивное разрушение эритроцитов
Гемоглобин — это белок, участвующий в переносе кислорода к клеткам, он содержится внутри эритроцита. Когда же происходит сильное разрушение эритроцитов в кровь высвобождаться большое количество гемоглобина, а селезенки и печень не успевают его расщеплять. При этом свободный гемоглобин выводится с мочой.
- малярия
- ожоги
- переливание крови
- гемолитическая болезнь
- повреждение мышечной ткани — контузия с гематомой, краш синдром
- отравления сульфаниламидными лекарственными средствами, фенолом, грибами
Начнем с того, что первоисточником уробилиногена является гемоглобин, из порфириновой части которого формируются молекулы непрямого билирубина, который в последствии в печени преобразуется в прямой и поступает в кишечник вместе с желчью. Далее, из билирубина формируется большое кол-во промежуточных веществ, отдельные из них всасываются в кровяное русло, другие вновь перерабатываются печенью, и лишь малая часть выводится вместе с мочой и называется уробилиногеном.
Следует отметить, что уробилиноген под действием солнечных лучей и при соединении с кислородом окисляется спустя пару часов, образуя уробилин. Оба эти вещ-ва, а также другие промежуточные соединения называют «уробилиноиды в моче». Наличие в моче уробилина называется уробилинурия, именно это вещество окрашивает мочу в темный цвет спустя время. Поэтому исследуемый материал нельзя держать долго на свету, иначе результат анализа будет иметь определенную погрешность.
Переоценить диагностическую ценность анализа мочи ubg трудно, это исследование весьма простое, доступное и высоко надежное, в медицинской диагностической практике оно просто незаменимо.
Начнем с того, что уробилиноген появляется в моче гораздо раньше билирубина в урине и крови. Поэтому, выявление ubg в анализе мочи, также как определение тимоловой пробы, АЛТ и АСТ крови, является одним из первых признаков развития гепатита.
Во-вторых, по уровню уробилиногена (точнее по его отсутствию) можно определить какого рода у пациента желтуха, механическая (из-за плохого оттока желчи) или же другого происхождения.
Также, уробилиноген в моче ubg является надежным индикатором функционального состояния печени, а также для отслеживания динамики улучшения или ухудшения течения того или иного заболевания.
Так или иначе, наличие уробилиногена в моче считается обязательной нормой, но только в допустимых пределах. Понижение или повышение нормативного показателя является важным диагностическим признаком и поводом для отправки пациента для более обширного обследования.
При исследовании материала в лабораторных условиях проводят специальный тест для определения пигмента в моче. По итогу теста может быть выявлена:
- Слабая положительная реакция ( );
- Положительная реакция ( );
- Резко выраженная положительная реакция ( ).
Повышенный уробилиноген в моче может сигнализировать о развитии у пациента следующих патологий:
- Заболевания печени (гепатит, цирроз, опухолевые образования в органе, острые печеночные инфекции);
- Острая интоксикация организма, спровоцировавшая значительный распад эритроцитов;
- Тяжелая степень гемолитической анемии (связанная с усиленным разрушением эритроцитов);
- Кишечная непроходимость или развитие острой/хронической инфекции тонкого и толстого кишечника;
- Внутренние кровотечения;
- Переливание крови, которая несовместима с кровью пациента;
- Тяжелые патологические состояния селезенки.
Иногда, увеличение уровня уробилиногена не связано с определенными недугами. Причиной может послужить сильное обезвоживание организма, напр., при интенсивном потоотделении или потери жидкости.
Обычно, женщины обеспокоены, если получают результат уробилиноген в моче 34, но паниковать раньше времени не стоит. Точную причину поможет выяснить ваш лечащий врач, и если изменения урины связаны с недостаточным потреблением жидкости, ее чрезмерной потерей или приемом некоторых лекарств, специалист порекомендует комплекс мер и соответствующие мероприятия для нормализации показателя.
В период вынашивания малыша в организме женщины происходят различные изменения, касающиеся работы практически всех органов и систем. Однако, ubg в анализе мочи норма для будущих мамочек не сильно отличается от обычных небеременных взрослых. Значительное отклонение от нормы в сторону повышения может свидетельствовать о патологиях печени.
Иногда, самые худшие ожидания врача и самой женщины могут не оправдаться, и повышение концентрации уробилиногена может быть связано с недостаточным количеством жидкости в организме. Обычно, это связано с неправильным питанием беременной или не соблюдением водно-солевого баланса в течении суток, прием некоторых видов медикаментов также могут привести к обезвоживанию.
Сдать мочу на желчные пигменты обычно назначают пациентам с подозрением на нарушение нормальной функциональности печени, желчекаменную болезнь или патологические процессы почек и системы крови. Расшифровку анализа мочи ubg должен осуществлять специалист. Вероятно, что для определения точного диагноза человеку назначат дополнительные анализы и обследование (узи, пробы и посевы).
После того, как определена причина отклонения, пациенту назначается курс лечения выявленного заболевания.
Чтобы не губить свое здоровье и держать все основные показатели в норме, необходимо постоянно укреплять свой иммунитет, следить за питанием и режимом дня, и вовремя лечить имеющиеся недуги и недомогания.
Будьте здоровы!
На наличие большого количества эритроцитов (крови) в моче указывает изменение ее цвета до красно-бурого – данное состояние именуется макрогематурией. Небольшое содержание эритроцитов можно определить только лабораторным путем.
В норме, эритроциты не выявляются, возможно, единичные проявления, не более 3 в поле зрения. Причинами содержания эритроцитов являются: инфекционные и воспалительные заболевания почек и мочевыводящих путей, злокачественные образования и травмы почек. Часто, следы крови в моче у мужчин свидетельствует о воспалении простаты в острой стадии.
Необходимым условием правильных результатов клинического исследования является соответствующая подготовка и сбор мочи. На состав и количество химических соединений в моче влияют многие факторы, способствующие ложноположительному или ложноотрицательному результату, а именно:
- медикаментозные препараты (если в составе присутствует кофеин, этиловый спирт, раувольфия, тринитрат глицерина, диуретики, обезболивающие, жаропонижающие, то в моче повышается глюкоза, креатинин и т.д.);
- алкогольные напитки, кофе, зеленый чай, напитки и еда с высокой концентрацией красителей в составе;
- слишком соленая и сладкая еда;
- несоблюдение норм гигиены.
Мочу собирают непосредственно после сна при первом мочеиспускании. Сразу после пробуждения необходимо провести гигиенические процедуры с использованием мыла и стерильных салфеток. Следует заранее подготовить стерильный контейнер, или использовать любую тщательно вымытую подходящую емкость.
Уробилиноген в моче
Уробилиноген содержится в свежевыпущенной моче, а при ее длительном стоянии он превращается в уробилин, который присутствует в организме здорового человека в малых дозах.
Повышенное содержание уробилина характерно при нарушении печени, когда она теряет способность выводить его с желчью, а также при закупорке желчного протока (к примеру, камнем).
Диагностика уробилинурии в медицинской практике важно для выявления причин возникновения желтухи и определения поражений печени.
Будьте здоровы!
Удельный вес мочи (sg)
Определение относительной плотности имеет огромное клиническое значение, так как эта величина отражает способность почек человека к концентрации и разведению. Удельный вес мочи измеряют по находящимся в ней веществам (различные соли, сахар, мочевая кислота).
Норма показателя для разных возрастовУвеличение относительной плотностиСнижение удельного веса
- Новорожденные – 1005-1017;
- 1-4 года – 1007-1016;
- 5-10 лет – 1011-1021;
- 11-15 лет – 1013-1024;
- Взрослые – 1010-1025 (в утренней моче – 1018-1026).
УВ более 1026 называется гиперстенурия. Это состояние наблюдается при:
- нарастании отеков;
- нефротическом синдроме;
- сахарном диабете;
- токсикозе беременных;
- введении рентгенконтрастных веществ.
Снижение УВ или гипостенурия (менее 1018) выявляется при:
- острое поражение канальцев почки;
- несахарный диабет;
- хроническая почечная недостаточность;
- злокачественное повышение артериального давления
- прием некоторых мочегонных средств
- обильное питье
Общий белок
В моче здорового человека содержится менее 0,002 г/л белка. Содержание данного элемента в количестве, превышающем норму, называется протеинурией, которая классифицируется на почечную и протеинурию мочевыводящих путей.
Для дифференциации протеинурии необходимо дополнительное исследование осадка мочи (по Нечипоренко, Аддису-Каховскому). Только при совокупном анализе всех показателей (эритроцитов, цилиндров, лейкоцитов) можно выявить причину содержания белка, это: патологические состояния почек (пиелонефрит, гломерулонефрит, туберкулез, амилоидоз и патологические состояния других органов: анемия, гипертония, сердечная недостаточность.
Белок в малых количествах может выявляться, если накануне перед сдачей анализа пациент потреблял белковую пищу, или выполнял тяжелые физические упражнения. Если в моче определяются следы белка, пациенту назначают повторный анализ.
Наличие малого объема белка в материале возможно при психоэмоциональных стрессах, физическом перенапряжении, спортивных соревнованиях, приеме холодного душа или ванны (ортостатическая протеинурия). Повышение общего белка в моче свыше 0,14 г/сутки (протеинурия) – грозный признак наличия некоторых болезней (см. причины появления слизи и белка в моче).
В исследуемой жидкости могут определяться особые виды белков:
- белок Бенс-Джонса – при миеломной болезни, микроглобулинемии Вальденстрема;
- β2-микроглобулин – при повреждении почечных канальцев.
Степень повышенияПоказателиПри каких патологиях встречаетсяЛегкая0,15-0,5 г/сутки
- нефритический синдром (острый гломерулонефрит);
- хронический гломерулонефрит;
- наследственные нефриты;
- тубулопатии;
- интерстициальный нефрит;
- мочекаменная болезнь
Умеренная0,5-2,0 г/сутки
- нефритический синдром (острый гломерулонефрит);
- хронический гломерулонефрит;
ВыраженнаяБолее 2,0 г/сутки
- нефротический синдром при остром гломерулонефрите;
- амилоидоз
Реакция рН мочи
Моча здорового человека имеет нейтральную или слабокислую реакцию. Изменение ее связано, в первую очередь, с характером питания (мясо или овощи), а также с целым рядом болезней. Следует помнить, что, если моча долго стоит при комнатной температуре, это ведет к ее защелачиванию и разрушению форменных элементов, тем самым изменяются результаты анализа.
Какие заболевания могут изменять рН материала?
Кислая реакция (рН < 5,0)Щелочная реакция (рН ≥ 7,0)
- в нормальных условиях (чрезмерное употребление мясной пищи);
- респираторный и метаболический ацидоз (диабетическая кома, острая сердечная недостаточность, ОПН);
- острый нефрит;
- подагра;
- туберкулез почки;
- гипокалиемия;
- прием некоторых медикаментов (аскорбиновая кислота, кортикотропный гормон)
- во время овощной диеты, обильном употреблении щелочных минеральных вод;
- метаболический и респираторный алкалоз (обильная рвота, гипервентиляция легких);
- острый период воспаления мочеполовой системы;
- гиперкалиемия;
- хроническая почечная недостаточность;
- под действием цитрата натрия, адреналина, альдостерона, бикарбонатов
Общая плотность SG
Показатель SG у здоровых людей может колебаться от 1,010 до 1,025. Отклонения от нормы при однократном исследовании не могут иметь решающего клинического значения. Требуются развернутые анализы, направленные на суточное определение плотности и ее колебания: пробы Рейзельмана, Зимницкого, на сухоядение, водяная.
Повышенная ОПл мочи наблюдается при обезвоживании, сахарном диабете, отеках, возникающих при патологиях сердца и почек.
Низкая ОПл – при чрезмерном питье, уменьшении отечности, долговременном голодании, недостаточности функции почек, несахарном диабете.
Когда назначаются анализы по Зимницкому?
Анализ по Зимницкому назначается для исследования функциональности почек.
Мнение эксперта
Ковалева Елена Анатольевна
Врач-Лаборант. Опыт работы в клинико-диагностической службе 14 лет.
Задать вопрос эксперту
Диагностическими факторами данного метода являются: плотность мочи и изменения ее числовых показателей в разных порциях, и диурез – соотношение между количеством потребленной и выделенной жидкости за 24 часа.
Нормальные показатели:
- Разность плотности мочи между наибольшим и наименьшим показателем не менее 0,012;
- Дневной диурез в два раза преобладает над ночным;
- Суточное количество мочи не менее 65 % и не более 85% от потребленной жидкости;
- Допускается минимальная плотность мочи – 1,005, максимальная – 1,030.
Отклонения свидетельствуют о заболеваниях почек: пиелонефрите и гломерулонефрите.
Глюкоза
Наличие глюкозы в моче (глюкозурия) напрямую связано с уровнем сахара крови: чем больше глюкозы в крови, тем больше ее будет выводиться из организма. Глюкозурия – первый признак САХАРНОГО ДИАБЕТА! Также сахар в моче может повышаться при:
- остром панкреатите;
- тиреотоксикозе;
- почечном диабете;
- стероидном диабете, болезни Иценко-Кушинга;
- сепсисе;
- опухолях головного мозга;
- феохромацитоме;
- действии отравляющих веществ (морфина, стрихнина, фосфора, хлороформа).
Но не во всех случаях глюкозурия свидетельствует о заболевании. В норме это состояние бывает при переедании сладкого, при постоянных стрессах и у беременных.
Кетоновые тела
Кетоновые тела – это продукты жирового обмена. В норме в организме их образуется очень малое количество. К кетонам относят: ацетон, β-оксимасляная кислота и ацетоуксусная кислота.
Обнаружение кетонов в моче (кетонурия или ацетон в моче) говорит о следующем:
- некомпенсированный сахарный диабет;
- безуглеводная диета, голодание, кахексия;
- избыточная продукция стероидных гормонов при опухолях мозга и коры надпочечников;
- ацетонемическая рвота у детей;
- дизентерия;
- тиреотоксикоз;
- акромегалия;
- эклампсия у беременных;
- интоксикация.